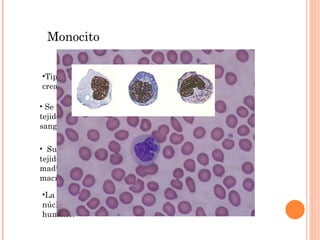
Su emplazamiento final es el tejido conectivo en el que se maduran transformándose en macrófagos tisulares. Monocito Tipo de leucocito que se crea en la médula ósea  Se reparte alrededor de todos los tejidos del cuerpo por el torrente sanguíneo. La forma que caracteriza su núcleo es la de un riñon humano.

Incrustar presentación
Descargado 223 veces








El tejido conectivo es responsable de la función inmune en mamíferos y aves, protegiendo al organismo mediante fagocitosis, el proceso por el cual las células envuelven y digieren antígenos, células muertas u organismos dañinos. El sistema mononuclear fagocítico incluye monocitos, macrófagos tisulares e células dendríticas, las cuales captan antígenos en diversos órganos y tejidos para procesarlos e iniciar una respuesta inmune.